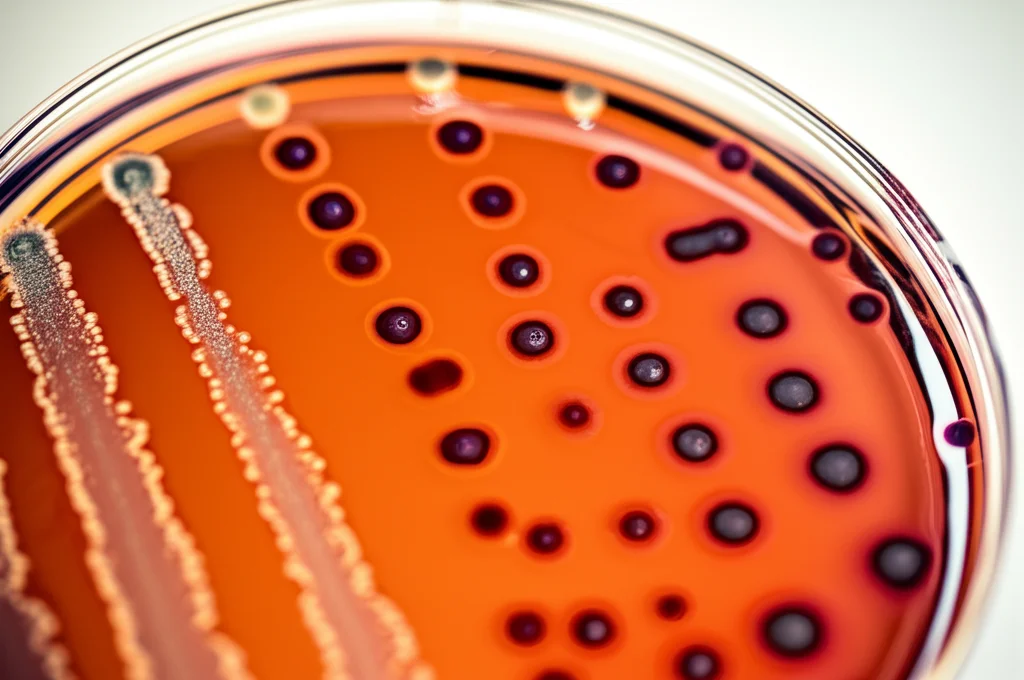
Macro fotografia, lente da 90 mm, che mostra colonie batteriche colorate che crescono su una piastra di agar cromogenica in una capsula di Petri in un ambiente di laboratorio ospedaliero, alti dettagli, illuminazione controllata, enfatizzando il tradizionale metodo di rilevamento dei CPE.

Superbatteri in Ospedale: Il Test Rapido Xpert Carba-R Batte la Cultura Tradizionale (e Fa Risparmiare!)?
Ciao a tutti! Oggi voglio parlarvi di un argomento che mi sta molto a cuore e che riguarda tutti noi: la lotta contro i superbatteri negli ospedali e come una nuova tecnologia potrebbe aiutarci a vincere una battaglia importante, quella dei costi e dell’efficienza. Mettetevi comodi, perché stiamo per addentrarci nel mondo affascinante (e un po’ preoccupante) dei Carbapenemase-Producing Enterobacterales, o CPE.
Cosa sono i CPE e perché dovremmo preoccuparci?
Partiamo dalle basi. Gli Enterobacterales sono una famiglia di batteri che normalmente vive nel nostro intestino. Fin qui, tutto ok. I problemi iniziano quando questi batteri sviluppano delle armi speciali, chiamate carbapenemasi. Si tratta di enzimi capaci di distruggere i carbapenemi, una classe di antibiotici potentissimi, spesso considerati l’ultima spiaggia per trattare infezioni gravi causate da batteri resistenti ad altri farmaci.
Quando questi batteri diventano resistenti ai carbapenemi (ecco i nostri CPE!), le infezioni diventano difficilissime da curare, portando a tassi di mortalità e morbilità più alti, per non parlare dei costi sanitari che lievitano. Pensate che in Inghilterra, il numero di casi di CPE è in costante aumento, anno dopo anno. È un problema globale, riconosciuto anche dall’Organizzazione Mondiale della Sanità.
Identificare rapidamente chi è portatore (colonizzato) o infetto da CPE è fondamentale per due motivi principali:
- Prevenire la diffusione ad altri pazienti vulnerabili all’interno dell’ospedale.
- Assicurare che il paziente riceva il trattamento più appropriato (se necessario).
Le linee guida, infatti, raccomandano di isolare i pazienti sospetti o confermati positivi ai CPE.
Lo screening: il metodo classico vs. l’innovazione
Ok, abbiamo capito il problema. Ma come facciamo a sapere se un paziente è portatore di CPE, soprattutto quelli considerati ad alto rischio (ad esempio, chi è stato ricoverato di recente all’estero o in ospedali con alta prevalenza di CPE)?
Il metodo tradizionale, lo standard attuale, si basa sulla coltura su terreni cromogenici. Si prende un campione (solitamente rettale) e si vede se i batteri crescono su un terreno specifico che cambia colore in presenza di CPE. Bello, no? Peccato che richieda tempo: di solito ci vogliono fino a 3 giorni per avere un risultato definitivo.
E qui casca l’asino. Tre giorni sono un’eternità in un ospedale. Durante questo tempo, per precauzione, il paziente ad alto rischio dovrebbe essere tenuto in isolamento. Questo comporta:
- Costi elevati per la stanza di isolamento e le misure di precauzione.
- Impegno di personale dedicato.
- Possibile disagio per il paziente.
- Occupazione di posti letto di isolamento che potrebbero servire ad altri.
E se poi il test risulta negativo? Abbiamo isolato inutilmente una persona per giorni, con tutti i costi e le implicazioni del caso.
Ed ecco che entra in gioco la tecnologia. Esiste un test molecolare rapido, chiamato Xpert Carba-R. Si basa sulla PCR (reazione a catena della polimerasi, la stessa tecnologia usata per i tamponi COVID, per intenderci) ed è in grado di rilevare i geni che producono le carbapenemasi più comuni (KPC, NDM, VIM, OXA-48, IMP) in soli 50 minuti! Un salto quantico rispetto ai 3 giorni della coltura.
La domanda sorge spontanea: questo test rapido, che sulla carta sembra fantastico, è anche conveniente dal punto di vista economico per il nostro Servizio Sanitario Nazionale (SSN)? Costa di più della coltura tradizionale? I benefici in termini di tempo compensano l’eventuale costo maggiore?
Lo studio: mettiamo i numeri sul tavolo
È proprio qui che entra in gioco il nostro studio. Abbiamo voluto fare i conti in tasca a questi due metodi di screening. Abbiamo sviluppato un modello economico (usando un approccio chiamato “cost-comparison” probabilistico, per i più tecnici) per confrontare i costi associati all’uso di Xpert Carba-R rispetto alla coltura tradizionale, dal punto di vista del SSN e dei servizi sociali personali.
Abbiamo immaginato una coorte di pazienti ad alto rischio di colonizzazione da CPE al momento del ricovero in ospedale. Abbiamo considerato un orizzonte temporale medio di circa 8 giorni (la durata media di un ricovero), aggiungendo altri 6 giorni circa per i pazienti effettivamente colonizzati (che quindi passerebbero più tempo in isolamento), per un totale di circa 14 giorni.
Nel nostro modello abbiamo inserito tanti parametri:
- I costi dei test (Xpert Carba-R è più caro della coltura, circa £23 contro £9 per test, anche se nel modello il costo medio per paziente ad alto rischio scende a £17.48 vs £9.10 perché non tutti vengono screenati).
- I costi dell’isolamento (giornalieri).
- I costi della degenza in reparto normale.
- I costi delle precauzioni da contatto.
- La sensibilità e la specificità dei due test (cioè quanto sono bravi a identificare correttamente i positivi e i negativi).
- Il tempo necessario per ottenere i risultati.
- La prevalenza di CPE (quanto sono diffusi).
- La probabilità che un paziente ad alto rischio venga effettivamente screenato e isolato preventivamente (abbiamo ipotizzato un 75% a causa dei limiti di capacità).
Abbiamo fatto girare il modello migliaia di volte (2000 iterazioni, per la precisione) cambiando leggermente i valori dei parametri per tenere conto dell’incertezza (analisi probabilistica).

Il verdetto: Xpert Carba-R conviene!
Ebbene sì, la notizia è buona! I risultati del nostro modello parlano chiaro: nonostante il costo unitario del test Xpert Carba-R sia più alto, il suo utilizzo risulta complessivamente più economico rispetto alla coltura tradizionale.
Quanto si risparmia? In media, abbiamo calcolato un risparmio incrementale di £818.28 per ogni paziente ad alto rischio screenato con Xpert Carba-R!
Com’è possibile? Semplice: il grosso del risparmio deriva dalla drastica riduzione del tempo di isolamento preventivo non necessario. Con Xpert Carba-R, se il test è negativo (e lo sai in meno di un’ora!), il paziente può essere spostato quasi subito in un reparto normale, liberando la stanza di isolamento e riducendo i costi associati.
Nel nostro modello:
- I costi medi di isolamento per paziente con Xpert Carba-R sono stati di £339.71.
- I costi medi di isolamento per paziente con la coltura sono stati di £1,670.37 (una bella differenza!).
Ovviamente, usando Xpert Carba-R, i costi della degenza in reparto normale aumentano (£2,734.60 vs £2,214.15), perché i pazienti negativi ci passano più tempo invece di stare in isolamento. Ma il bilancio finale è nettamente a favore del test rapido.
Abbiamo anche fatto delle analisi di sensibilità, cioè abbiamo visto cosa succede cambiando alcuni parametri chiave (come la specificità dei test o il tempo per avere i risultati). Risultato? La conclusione non cambia: Xpert Carba-R rimane cost-saving in tutti gli scenari ragionevoli che abbiamo testato.
Perché questo risultato è importante (e cosa manca)
Questo studio, seppur preliminare (è un “early economic model”), suggerisce fortemente che adottare Xpert Carba-R per lo screening dei pazienti ad alto rischio di CPE potrebbe portare a risparmi significativi per il SSN. Risparmi che derivano principalmente dall’evitare isolamenti inutili.
Pensateci: meno isolamenti inutili significa:
- Letti di isolamento liberi per chi ne ha davvero bisogno.
- Meno stress per i pazienti.
- Personale sanitario che può dedicarsi ad altre attività.
- Potenziale miglioramento del flusso dei pazienti in ospedale.
Altri studi, come quello di Moloney et al., avevano già trovato risultati simili, stimando risparmi comparabili con strategie basate su PCR.

C’è da dire che il nostro modello è stato conservativo. Non abbiamo quantificato esplicitamente alcuni potenziali benefici aggiuntivi di Xpert Carba-R, come:
- La riduzione della trasmissione secondaria di CPE ad altri pazienti (identificare e isolare rapidamente un positivo vero previene ulteriori contagi).
- Il costo opportunità di liberare stanze di isolamento (che potrebbero essere usate per altri pazienti critici o procedure).
È molto probabile, quindi, che i risparmi reali associati all’uso di Xpert Carba-R siano ancora maggiori di quelli che abbiamo stimato. Immaginate l’impatto in ospedali con alta prevalenza di CPE o con capacità di isolamento limitata: un test rapido e accurato potrebbe fare davvero la differenza.
Conclusioni (provvisorie ma promettenti)
Insomma, sulla base della nostra analisi economica, l’uso di Xpert Carba-R per lo screening dei pazienti ad alto rischio di CPE sembra essere una strategia vincente dal punto di vista dei costi rispetto alla coltura tradizionale nel contesto del SSN.
Certo, ci sono delle limitazioni (non abbiamo modellato la trasmissione, abbiamo fatto delle assunzioni sui costi e sulle pratiche ospedaliere che possono variare). Serviranno ulteriori analisi, magari studi di cost-effectiveness più completi, per confermare questi risultati e supportare decisioni su larga scala per l’implementazione di questa tecnologia nel SSN.
Ma il segnale è forte e chiaro: investire in tecnologie diagnostiche rapide come Xpert Carba-R potrebbe non solo migliorare la gestione dei pazienti e la lotta alla diffusione dei superbatteri, ma anche far risparmiare risorse preziose al nostro sistema sanitario. E questa, lasciatemelo dire, è una notizia che fa ben sperare!
Fonte: Springer
